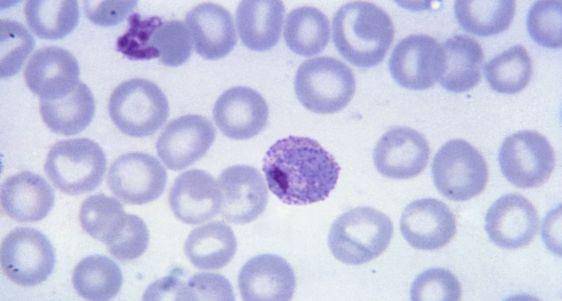
5 Jenis Malaria yang Berbahaya untuk Kesehatan, Kenali Gejalanya! 3.jpg

Demam tinggi yang datang secara berkala.
Menggigil dan berkeringat, terutama setelah demam reda.
Sakit kepala yang terus-menerus.
Mual dan muntah.
Nyeri otot dan sendi.
Kelelahan ekstrem.
Diare (pada beberapa kasus).
Anemia akibat penghancuran sel darah merah.
Pembesaran limpa.
Kejang atau kehilangan kesadaran (pada kasus berat).
5 Jenis Malaria yang Berbahaya untuk Kesehatan, Kenali Gejalanya!

- Malaria Plasmodium Falciparum adalah jenis paling berbahaya dan resisten terhadap obat anti-malaria.
- Plasmodium vivax dapat menyebabkan komplikasi serius dan fatal pada individu dengan sistem kekebalan tubuh yang lemah.
- Plasmodium malariae bisa bertahan dalam tubuh selama bertahun-tahun dan menyebabkan masalah ginjal serius.
Kamu pasti sudah familier dengan malaria, penyakit yang ditularkan lewat gigitan nyamuk. Setiap tahun, lebih dari 200 juta kasus tercatat akibat nyamuk Anopheles.
Menurut World Health Organization (WHO), malaria menjadi salah satu penyebab kematian di negara berkembang. Setiap jenis malaria memiliki karakteristik berbeda, dan beberapa di antaranya lebih mematikan dari yang lain.
Karena itu, Popmama.com akan membantu kamu melihat 5 jenis malaria yang berbahaya untuk kesehatan. Scroll lebih lanjut informasinya di sini, ya.
1. Malaria Plasmodium Falciparum

Malaria yang disebabkan oleh parasit Plasmodium falciparum adalah jenis yang paling berbahaya dan seringkali mematikan. Menurut The Lancet, jenis ini dapat menyebabkan malaria berat dan kerusakan organ vital.
Selain itu, Plasmodium falciparum cenderung resisten terhadap beberapa obat anti-malaria. Centers for Disease Control and Prevention (CDC) menemukan, bahwa resistensi terhadap klorokuin yang merupakan obat utama malaria kini semakin meningkat.
2. Malaria Plasmodium vivax
Plasmodium vivax adalah jenis malaria yang lebih umum ditemukan di kawasan Asia dan Amerika Latin. Meskipun tidak seberbahaya P. falciparum, tetap dapat menyebabkan gejala serius.
Jenis malaria ini dapat menyebabkan komplikasi dan menyebabkan anemia berat. Di beberapa kasus, Plasmodium vivax juga dapat berakibat fatal pada individu dengan sistem kekebalan tubuh yang lemah.
3. Malaria Plasmodium ovale

Plasmodium ovale adalah jenis malaria yang jarang ditemukan namun tetap berbahaya. Melansir dari Clinical Infectious Diseases, jenis ini bisa menyebabkan relaps yang parah dan berisiko tinggi pada penderita dengan kekebalan tubuh rendah.
Meskipun gejalanya sering kali lebih ringan, Plasmodium ovale memiliki kemampuan untuk bertahan lebih lama dalam tubuh. Relaps yang terjadi dapat menyebabkan gejala lebih berat dan memperburuk kesehatan pasien.
4. Malaria Plasmodium malariae

Plasmodium malariae adalah jenis malaria yang lebih jarang, namun tetap bisa sangat berbahaya. Meskipun lebih jarang, Plasmodium malariae sering kali tidak terdeteksi pada pemeriksaan awal.
Karena sifatnya jarang terdeteksi, Plasmodium malariae bisa bertahan dalam tubuh manusia selama bertahun-tahun. Malaria jenis ini dapat menyebabkan masalah ginjal serius, termasuk sindrom nefrotik, yang mengarah pada gagal ginjal jika tidak segera diobati.
5. Malaria Plasmodium knowlesi

Plasmodium knowlesi adalah jenis malaria yang berasal dari primata dan kini banyak dilaporkan pada manusia di Asia Tenggara. Jenis malaria ini memiliki potensi menyebabkan malaria berat, dengan gejala yang lebih cepat berkembang dan menyebabkan gagal ginjal akut.
Penularannya lewat gigitan nyamuk jenis tertentu membuatnya lebih sulit untuk dikendalikan. Jika tidak cepat terdeteksi, infeksi ini bisa berakibat fatal karena berkembang dengan cepat.
Gejala Malaria yang Perlu Diwaspadai

Malaria merupakan penyakit serius yang disebabkan oleh parasit dan ditularkan melalui gigitan nyamuk Anopheles. Berikut adalah beberapa gejala umum malaria yang sebaiknya kamu waspadai:
Pengobatan yang Aman dan Efektif untuk Mengatasi Penyakit Malaria

Pengobatan malaria bergantung pada jenis parasit penyebab infeksi dan tingkat keparahan penyakit. Umumnya, melibatkan kombinasi obat untuk membasmi parasit dan mencegah komplikasi.
1. Artemisinin Kombinasi Terapi (ACT)
ACT adalah pengobatan standar untuk malaria yang disebabkan oleh Plasmodium falciparum dan jenis lainnya. Pengobatan ini menggabungkan artemisinin dengan obat antimalaria lainnya untuk meningkatkan efektivitas dan mengurangi resistensi parasit.
2. Klorokuin
Klorokuin masih digunakan untuk mengobati malaria yang disebabkan oleh Plasmodium vivax, Plasmodium malariae, dan Plasmodium ovale. Namun, resistensi terhadap klorokuin semakin meningkat, terutama untuk P. falciparum.
3. Primaquin
Untuk mencegah kekambuhan malaria akibat Plasmodium vivax dan Plasmodium ovale, primaquin digunakan untuk menghancurkan bentuk parasit yang dorman di hati.
4. Mefloquine dan Lumefantrine
Jika resistensi terhadap klorokuin terjadi, mefloquine atau lumefantrine bisa menjadi pilihan untuk mengobati malaria Plasmodium falciparum yang lebih berat.
5. Pengobatan simtomatik
Pada kasus malaria berat, pengobatan simtomatik diperlukan untuk menangani gejala seperti demam tinggi, dehidrasi, dan kerusakan organ. Ini dapat melibatkan cairan infus, obat penurun demam, dan terapi untuk organ yang terpengaruh.
Nah, itu dia 5 jenis malaria yang berbahaya untuk kesehatan. Dengan melakukan deteksi cepat dan pengobatan tepat, kita dapat mengurangi risiko komplikasi yang ditimbulkan oleh penyakit ini.


-50392b2d31f9be3acc109116754520b4.png)
















